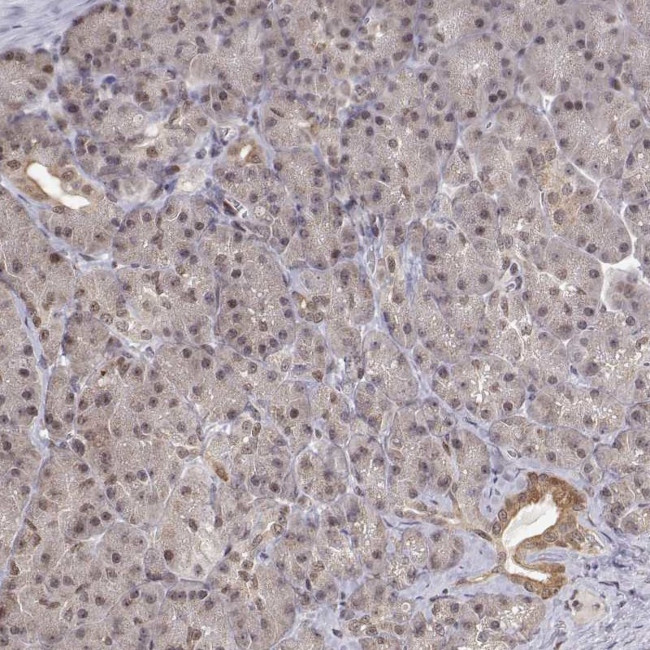
BRCA1 Antibody in Immunohistochemistry (Paraffin) (IHC (P))

Search
Invitrogen
BRCA1 Polyclonal Antibody
{{$productOrderCtrl.translations['antibody.pdp.commerceCard.promotion.promotions']}}
{{$productOrderCtrl.translations['antibody.pdp.commerceCard.promotion.viewpromo']}}
{{$productOrderCtrl.translations['antibody.pdp.commerceCard.promotion.promocode']}}: {{promo.promoCode}} {{promo.promoTitle}} {{promo.promoDescription}}. {{$productOrderCtrl.translations['antibody.pdp.commerceCard.promotion.learnmore']}}
产品信息
PA5-84339
种属反应
宿主/亚型
分类
类型
抗原
偶联物
形式
浓度
规格
纯化类型
保存液
内含物
保存条件
运输条件
RRID
产品详细信息
Immunogen sequence: GRNHQGPKRA RESQDRKIFR GLEICCYGPF TNMPTDQLEW MVQLCGASVV KELSSFTLGT GVHPIVVVQP DA
Highest antigen sequence indentity to the following orthologs: Rat - 68%, Mouse - 65%.
靶标信息
BRCA1 (breast and ovarian cancer susceptibility protein 1) is a nuclear phosphoprotein that plays a role in maintaining genomic stability and acts as a tumor suppressor in combination with other tumor suppressors, DNA damage sensors, and signal transducers to form a large multi-subunit protein complex known as BASC (for BRCA1 associated genome surveillance complex). BRCA1 associates with RNA polymerase II, and through the C terminal domain, also interacts with histone deacetylase complex. The BRCA1 protein thus plays a role in transcription, DNA repair of double-stranded breaks, and recombination. Mutations in the BRCA1 gene are responsible for approximately 40% of inherited breast cancers and more than 80% of inherited breast and ovarian cancers. Alternative splicing plays a role in modulating the subcellular localization and physiological function of this gene. Many alternatively spliced transcript variants, some of which are disease-associated mutations, have been described for this gene, but the full-length natures of only some of these variants has been described. A related pseudogene, which is also located on chromosome 17, has been identified.
仅用于科研。不用于诊断过程。未经明确授权不得转售。
篇参考文献 (0)
生物信息学
蛋白别名: brca 1; brca-1; BRCA1/BRCA2-containing complex, subunit 1; breast and ovarian cancer susceptibility protein 1; breast cancer 1 early onset; breast cancer 1, early onset; Breast cancer type 1 susceptibility protein; breast cancer type 1 susceptibility protein isoform p.23; breast cancer type 1 susceptibility protein, isoform p.10; breast cancer type 1 susceptibility protein, isoform p.11; breast cancer type 1 susceptibility protein, isoform p.12; breast cancer type 1 susceptibility protein, isoform p.13; breast cancer type 1 susceptibility protein, isoform p.14; breast cancer type 1 susceptibility protein, isoform p.15; breast cancer type 1 susceptibility protein, isoform p.16; breast cancer type 1 susceptibility protein, isoform p.17; breast cancer type 1 susceptibility protein, isoform p.18; breast cancer type 1 susceptibility protein, isoform p.19; breast cancer type 1 susceptibility protein, isoform p.20; breast cancer type 1 susceptibility protein, isoform p.21; breast cancer type 1 susceptibility protein, isoform p.22; breast cancer type 1 susceptibility protein, isoform p.24; breast cancer type 1 susceptibility protein, isoform p.25; breast cancer type 1 susceptibility protein, isoform p.26; breast cancer type 1 susceptibility protein, isoform p.27; breast cancer type 1 susceptibility protein, isoform p.28; breast cancer type 1 susceptibility protein, isoform p.29; breast cancer type 1 susceptibility protein, isoform p.30; breast cancer type 1 susceptibility protein, isoform p.31; breast cancer type 1 susceptibility protein, isoform p.32; breast cancer type 1 susceptibility protein, isoform p.33; breast cancer type 1 susceptibility protein, isoform p.34; breast cancer type 1 susceptibility protein, isoform p.35; breast cancer type 1 susceptibility protein, isoform p.36; breast cancer type 1 susceptibility protein, isoform p.37; breast cancer type 1 susceptibility protein, isoform p.38; breast cancer type 1 susceptibility protein, isoform p.39; breast cancer type 1 susceptibility protein, isoform p.40; breast cancer type 1 susceptibility protein, isoform p.41; breast cancer type 1 susceptibility protein, isoform p.42; breast cancer type 1 susceptibility protein, isoform p.6; breast cancer type 1 susceptibility protein, isoform p.7; breast cancer type 1 susceptibility protein, isoform p.8; breast cancer type 1 susceptibility protein, isoform p.9; BROVCA12; Delta772-3095; early onset breast cancer 1; Fanconi anemia, complementation group S; influences susceptibility to breast and ovarian cancer; OTTHUMP00000212147; OTTHUMP00000212148; OTTHUMP00000212149; OTTHUMP00000212150; OTTHUMP00000212151; OTTHUMP00000212155; protein phosphatase 1, regulatory subunit 53; RING finger protein 53; RING-type E3 ubiquitin transferase BRCA1; unnamed protein product
基因别名: BRCA1; BRCAI; BRCC1; BROVCA1; FANCS; IRIS; PNCA4; PPP1R53; PSCP; RNF53
UniProt ID: (Human) P38398
Entrez Gene ID: (Human) 672